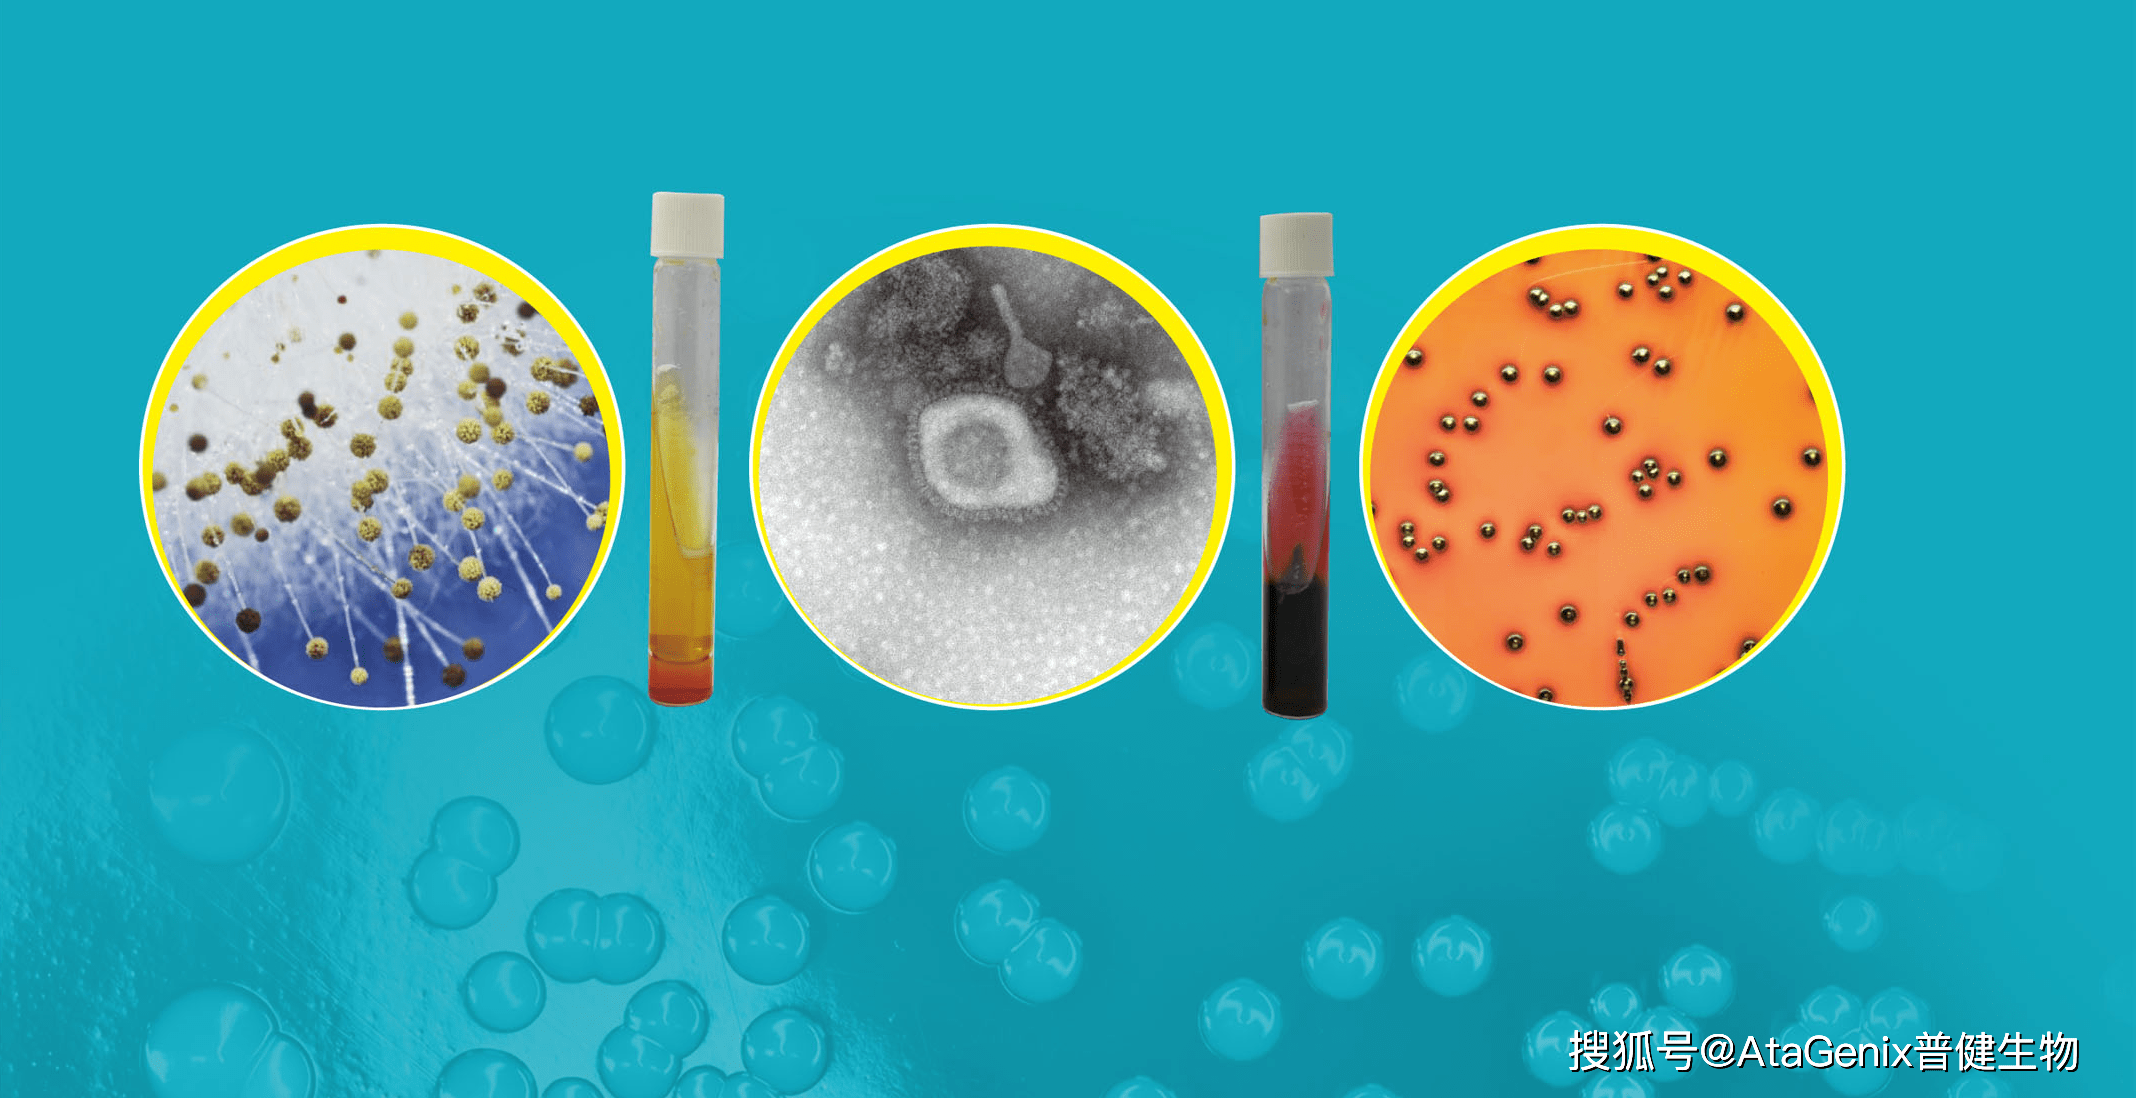
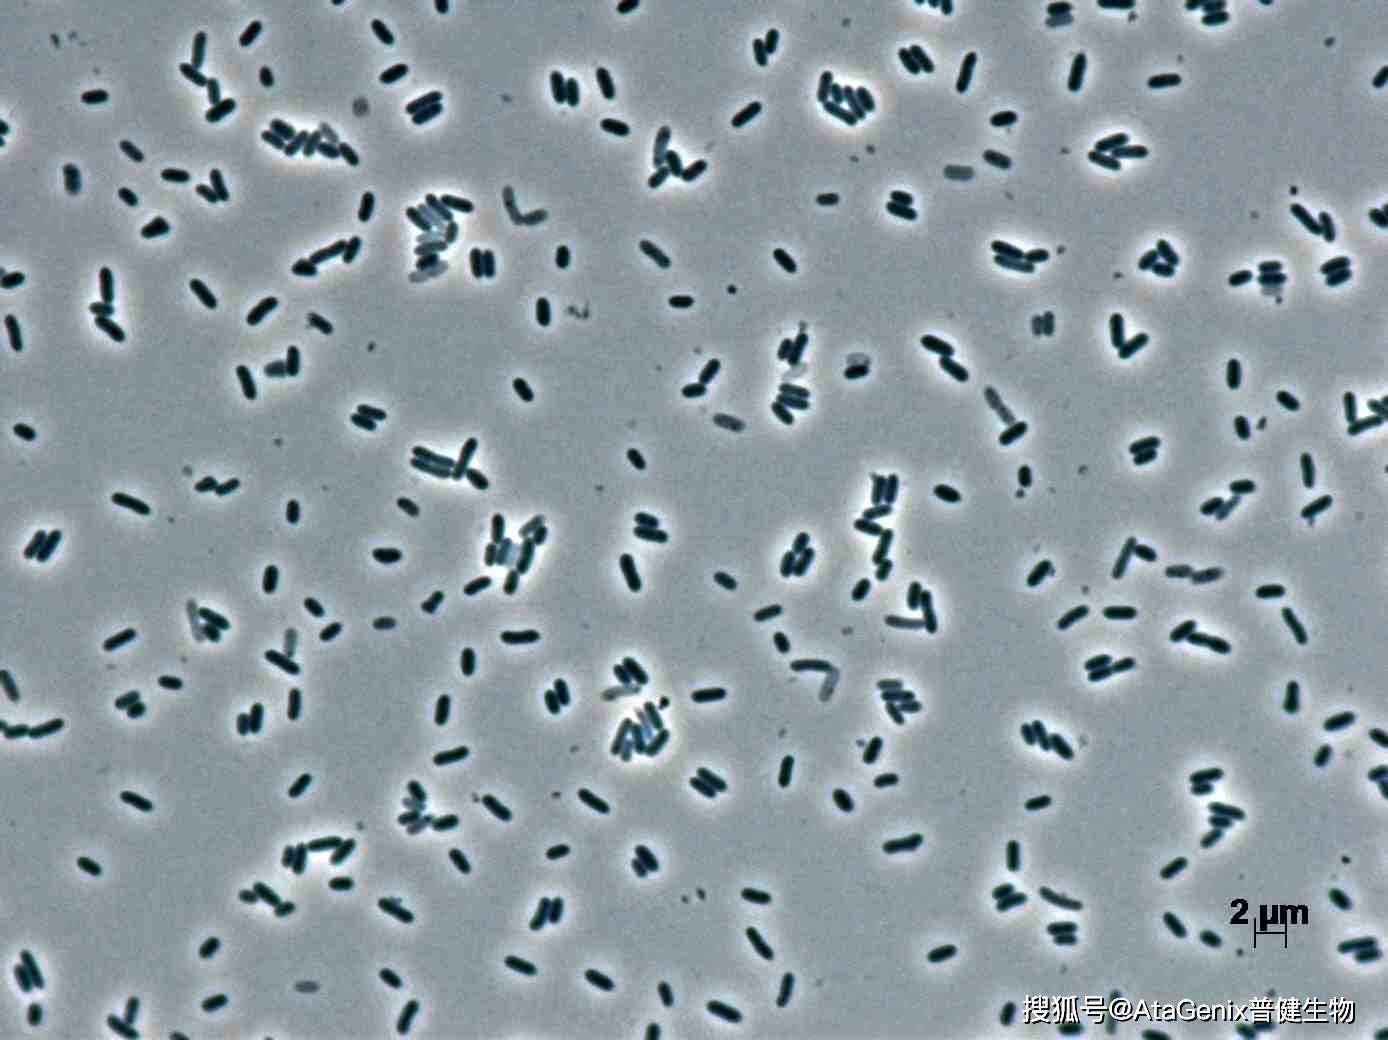

五一小长假出游,警惕微生物食源性腹泻
五一小长假马上就要到了,相信不少朋友已经呼朋唤友,准备好了外出旅行、野餐、徒步等户外活动。五月是春夏之交,气温上升,各种病原体生长繁殖日趋活跃,在户外更容易接触到细菌和寄生虫,往往容易引发食源性疾病,从而导致腹泻。腹泻不仅影响出游体验,也会对身体健康产生影响。
引起食源性疾病的
常见微生物类型
1984年世界WHO将“食源性疾病”一词作为正式的专业术语,以代替历史上使用的“食物中毒”一词,食源性疾病指致病因子通过食物进入人体而导致感染或者中毒,也就是我们常说的“病从口入”。大部分食源性疾病是由病毒、细菌、蠕虫和真菌引起的。这些微生物小到我们肉眼都看不见,隐匿在我们的环境和各种食物中,稍不留神就可能遭到它们的袭击,导致食源性疾病的发生。
大多数由致病菌引起的食源性疾病主要以消化系统症状为主,就是人们常说的“上吐下泻”。但有些食源性致病菌感染后除了消化系统症状以外,还会引起严重的并发症。食源性疾病的发病率居各类疾病总发病率的前列,是当前世界上最突出的卫生问题。
不可不防的沙门氏菌
沙门氏菌(Salmonella)常污染禽、肉、蛋、鱼、奶类及其制品等,被污染后的食物看起来似乎并没有变化,进食后却可致病。常见的感染症状是发热、呕吐、腹泻、腹痛等,重者可引起脱水、休克,甚至引发败血症。

沙门氏菌属是一组形态、生化性状及抗原构造相似的革兰氏阴性杆菌,无芽胞,无荚膜,多数细菌有周身鞭毛和菌毛,有动力。
根据抗原结构的不同,可分为菌体抗原(O抗原)、鞭毛抗原(H抗原)和表面抗原(Vi抗原)三种。按菌体抗原结构的不同,可分为A~E等50个菌群,再按鞭毛抗原的不同而鉴别组内的各血清型。目前已检测出沙门氏菌血清型有2000多个,与人类有关的血清型约有50个。
产“毒”的金黄色葡萄球菌
金黄色葡萄球菌(Staphylococcus aureus,S. aureus)在健康人的咽喉、鼻腔、皮肤上常有它的踪迹,尤其伤口化脓感染处和上呼吸道感染者的鼻腔更是它的主要聚集地。常污染蛋白质或淀粉含量丰富的食品,如奶和奶制品、肉和肉制品、糕点、剩饭等。摄入含有金黄色葡萄球南肠毒素的食物后,会出现恶心、剧烈吐、腹痛、腹泻等急性胃肠炎症状。易感人群为儿童,且年龄越小越敏感。

金黄色葡萄球菌隶属于葡萄球菌属(Staphylococcus),典型的金黄色葡萄球菌为球型,直径0.8μm左右,显微镜下排列成葡萄串状,无芽胞、鞭毛,大多数无荚膜,是革兰氏阳性菌的代表,具有抗干燥、耐热、耐低温、耐高渗的特性。
“冰箱杀手”李斯特菌
单核增生李斯特氏菌(Listeriamonocytogens)又称单增李斯特氏菌、李斯特菌,是李斯特氏菌属的8个菌种中对人类致病的力最强的菌种,生命力顽强,在冰箱冷藏温度4℃下仍可以生长繁殖,常污染肉、奶及其制品、水产品等,在生肉和即食食品中污染率最高。单增李斯特菌一般导致肠道感染,病人会出现发热、肌肉酸痛、恶心、呕吐等症状,也能引起严重的脑膜炎和败血症,发病率虽低,病死率却较高。

李斯特菌是一种革兰氏阳性、无芽孢、能动的兼气厌氧杆菌。它属过氧化氢酶阳性、氧化酶阴性,并具β型溶血(完全溶血)的特征,能摧毁红血球。以光学显微镜观察时,能看到李斯特菌具有翻滚运动性。李斯特菌在室温环境下(20−25℃)能以周生鞭毛活跃的活动,但温度到了人体体温(37℃)时便不能合成鞭毛。
重口味的副溶血性弧菌
副溶血性弧菌(Vibrio Parahaemolyticus,VP)天然存在于海水、沿海环境、海底沉积物和鱼虾贝类等海产品中且生命力十分顽强,在抹布和砧板上能生存1个月以上,是我国沿海地区最为常见的食源性病原菌。副溶血性弧菌感染高峰在夏秋季,最常见的症状是急性胃肠炎,一般恢复较快,少数病人可发展至脱水、休克。

副溶血弧菌系弧菌科弧菌属,革兰阴性菌,兼性厌氧菌,嗜盐畏酸,为多形态杆菌或稍弯曲弧菌。在不同培养基中菌体形态差异较大,有卵圆形、棒状、球杆状、梨状、弧形等多种形态。两极浓染。菌体一端有单鞭毛,运动活泼。无芽胞、无荚膜。
婴幼儿的敌人:克罗诺杆菌
克罗诺杆菌(Cronobacter,原阪崎肠杆菌)是存在于环境中的一种微生物,具有耐热、耐干燥等特点,可长时间存在于干燥的环境中,是污染婴幼儿配方奶粉的主要致病菌,能感染新生儿,并导致严重的坏死性小肠结肠炎、菌血症和脑膜炎等疾病。
克罗诺杆菌为革兰氏阴性无芽孢杆菌、周身鞭毛,有动力,大多数产黄色素。该菌耐高渗透压、抗干燥、对温度的抗性比大多数革兰氏阴性菌强,这是它不同于其他食源性致病菌的重要特征。
引起腹泻的诺如病毒
诺如病毒(Norovirus, NV),又称诺瓦克病毒(Norwalk Viruses, NV)是人类杯状病毒科(Human Calicivirus, HuCV)中诺如病毒属的一种病毒。该病毒病原于1968年首次从美国诺瓦克市暴发的急性腹泻患者的粪便中分离出来。此后,世界各地陆续自胃肠炎患者粪便中分离出多种形态与之相似但抗原性略异的病毒样颗粒,均以发现地点命名,如:Hawaii Virus(HV)、Snow Mountain Virus(SMV)、Mexico Virus(MxV)和Southampton Virus(SOV)等,先被称为小圆结构病毒(Small Round Structural Virus, SRSV),后称为诺瓦克样病毒(Norwalk-likevirus, NLV)。经过人们不懈的研究,终于发现此病毒为一组形态相似、抗原性略有不同的病毒颗粒,也是引发急性病毒性胃肠炎(AGE)的主要原因。最终于2002年8月第八届国际病毒命名委员会批准该病毒名称为诺如病毒(Norovirus, NV)。而在1995年,中国报道了首例诺如病毒感染,之后全国各地先后发生多起诺如病毒感染性腹泻暴发疫情。

诺如病毒直径约为26~35nm,无包膜,表面粗糙,球形,呈二十面体对称;现有样本均为急性胃肠炎病人的粪便中分离,目前不能在细胞或组织中培养,也没有合适的动物感染模型;基因组为全长约7.7k的单股正链RNA。

如何预防微生物性食源性疾病
小普温馨提醒,随着气温升高,各种致病微生物容易滋生,在我们享受欢乐的五一假期时,也一定要注意食品卫生,做到“五要”:
要保持清洁,注意勤洗手,保持餐具、厨具和厨房环境清洁;
要生熟分开,食物、加工食物的厨具、容器要生熟分开,避免交叉污染;
要煮熟烧透,即肉、禽、蛋、海产品等食物煮熟烧透;
要科学保存食物,熟食在室温下存放时间不超过2小时,室温或冷藏放置的熟食再次食用前应彻底加热;
要食物原料可靠,从正规渠道购买新鲜的蔬菜、水果、谷物等食材。